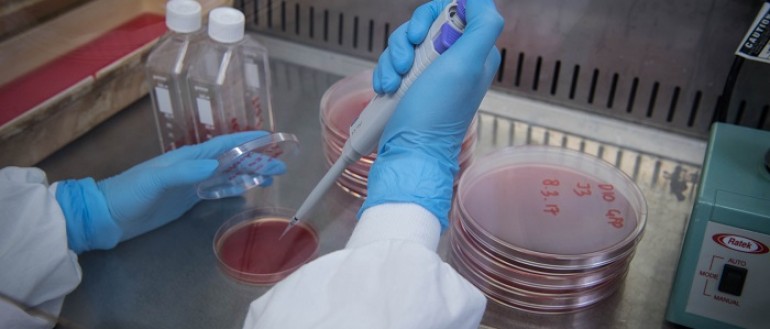

Laboratory-based biomedical research is a vital component of Menzies' activities. Some projects are entirely laboratory based, while others encompass both clinical and laboratory-based aspects.
The laboratory complex in the Menzies John Mathews Building provides facilities for experimentation in the fields of microbiology, parasitology, molecular biology, immunology and biochemistry. The major research areas in the laboratory include melioidosis, malaria, respiratory, ear, skin and sexually transmitted infections.
Laboratory-based researchers are also active in developing new methods for genetic, immunological and biochemical and bioinformatic analyses. Laboratory capacities include bio-containment to PC-3 level, recombinant DNA technology, with associated certification from the Office of the Gene Technology Regulator, flow cytometry, biochemical separations and real-time PCR.
Laboratory-based researchers are becoming increasingly involved in genomics and computational capacity to support this is rapidly being developed.
The laboratory also provides secure storage for Menzies' very large and immensely valuable collection of frozen clinical and biological material. The entire complex is managed and maintained by a dedicated team that provides expert and efficient support to all laboratory researchers.
Menzies' laboratory-based researchers are particularly active in providing opportunities for school students and university undergraduates to gain research experience. Given the small size and isolated location of Darwin, and the unique nature of the Menzies laboratory in this part of the world, this is of great importance in maximising opportunities for Top End residents to be aware of and pursue careers in biomedical research.